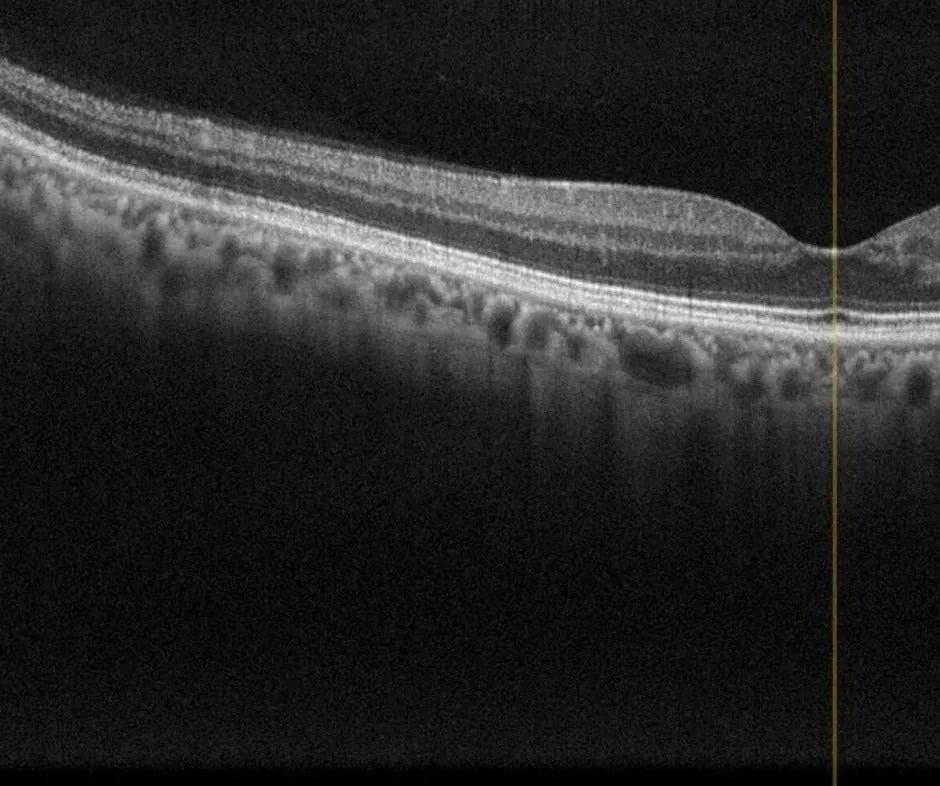

Surrey Eye Exam Optiview Eye Clinic

At Optiview Eye Clinic we combine technological advancement and clinical experience to enhance patient care and ensure our patients receive the best eye care available.
Our optometrists see patients of all ages for and a referral is not required to schedule an appointment.

Optomap Ultra-Wide Field Imaging
Nikon Optomap California Ultra-Wide Field Imaging allows for imaging of 200 degrees of retina in a single shot, often without the need for dilating drops. This allows for early detection and monitoring of many eye conditions such as diabetic retinopathy, retinal holes, tears, and detachments, ocular tumors, and more.
Ocular Coherence Tomography (OCT)
We utilize Zeiss OCT scanning laser images of the retinal layers and optic nerve for lifelong monitoring of critical eye conditions like glaucoma and macular degeneration. In addition macular edema due to diabetic retinopathy, macular degeneration, and many other sight threatening conditions can be detected early.

Humphrey Visual Field Testing
Zeiss Humphrey Visual Field testing is the standard of care for management of several conditions including glaucoma, detection of brain tumors, strokes, plaquenil retinopathy, and more. Its also sometimes used for specialized visual field testing by special request from ICBC, the RCMP, and Transport Canada including the Esterman Binocular Visual Field test.

Nidek Tonoref III
The Nidek Tonoref III allows for quick and highly accurate measurement of several diagnostics including autorefraction, autotonometry (intraocular pressure), autokeratometry (corneal curvature), pachymetry (corneal thickness), and more in a single scan.

Surrey Eye Exam: Advanced Vision Care You Can Trust
To ensure that your vision is clear and that your eye health is preserved in the long term, it is recommended to have a complete Surrey Eye Exam. Combining hi-tech technology with clinical acumen, we provide precise diagnoses and personalized care to patients of all ages at the Optiview Eye Clinic. None of these needs referrals, so you can readily obtain professional eye care when it is necessary.
Comprehensive and Patient-Focused Exams
Our Surrey Eye Exam is more than a simple eye check. We check on your general eye health, check the performance of your eyes, and check on the early indications of eye conditions. You may require a regular check-up or following up on already existing issues, our optometrists make sure its a comprehensive and comfortable experience.

Cutting-Edge Diagnostic Technology
We use the latest technology to give accurate and specific measurements. The ultra-wide field retinal imaging enables us to have a wide vision of the retina, thereby aiding in the detection of such conditions as retinal tears, diabetic eye disease, and other abnormalities at the initial stage. The Optical Coherence Tomography (OCT) offers detailed visualization of the retinal layers and optic nerve with the aid of qualitative imaging of glaucoma and macular degeneration.
Advanced Testing for Accurate Results
Visual field testing is also provided at our clinic to test peripheral vision and neurological or eye conditions. Moreover, the latest diagnostic instruments can determine the eye pressure, corneal thickness and refractive error fast and with high precision, thus making sure that you are fully assessed in the process of your Surrey Eye Exam.
Common Questions
Children should have their first routine eye exam between the age of 6-12 months. See Healthlink BC for more info.
Please bring the following items with you:
- A list of your current medications
- Care card
- Private insurance number, if applicable (in many cases we can direct bill your insurance to reduce or eliminate out of pocket expenses for eye exams, glasses, and contact lenses)
- All current eyeglasses including reading glasses (if applicable)
- Your contact lenses if you wear contact lenses and require a new contact lens prescription
Expect to spend about 45 minutes to 1 hour at your eye examination appointment
To schedule an appointment online please click this link or call our front desk at 604-593-5534.
Our office is located at 7500 120th street Unit 106 in Surrey, BC. We are in the same plaza as HSBC and Shoppers Drug Mart. We have convenient and free parking available in front of our clinic.
No, patients may contact us directly with appointment requests.
Yes, we are accepting patients of all ages!
